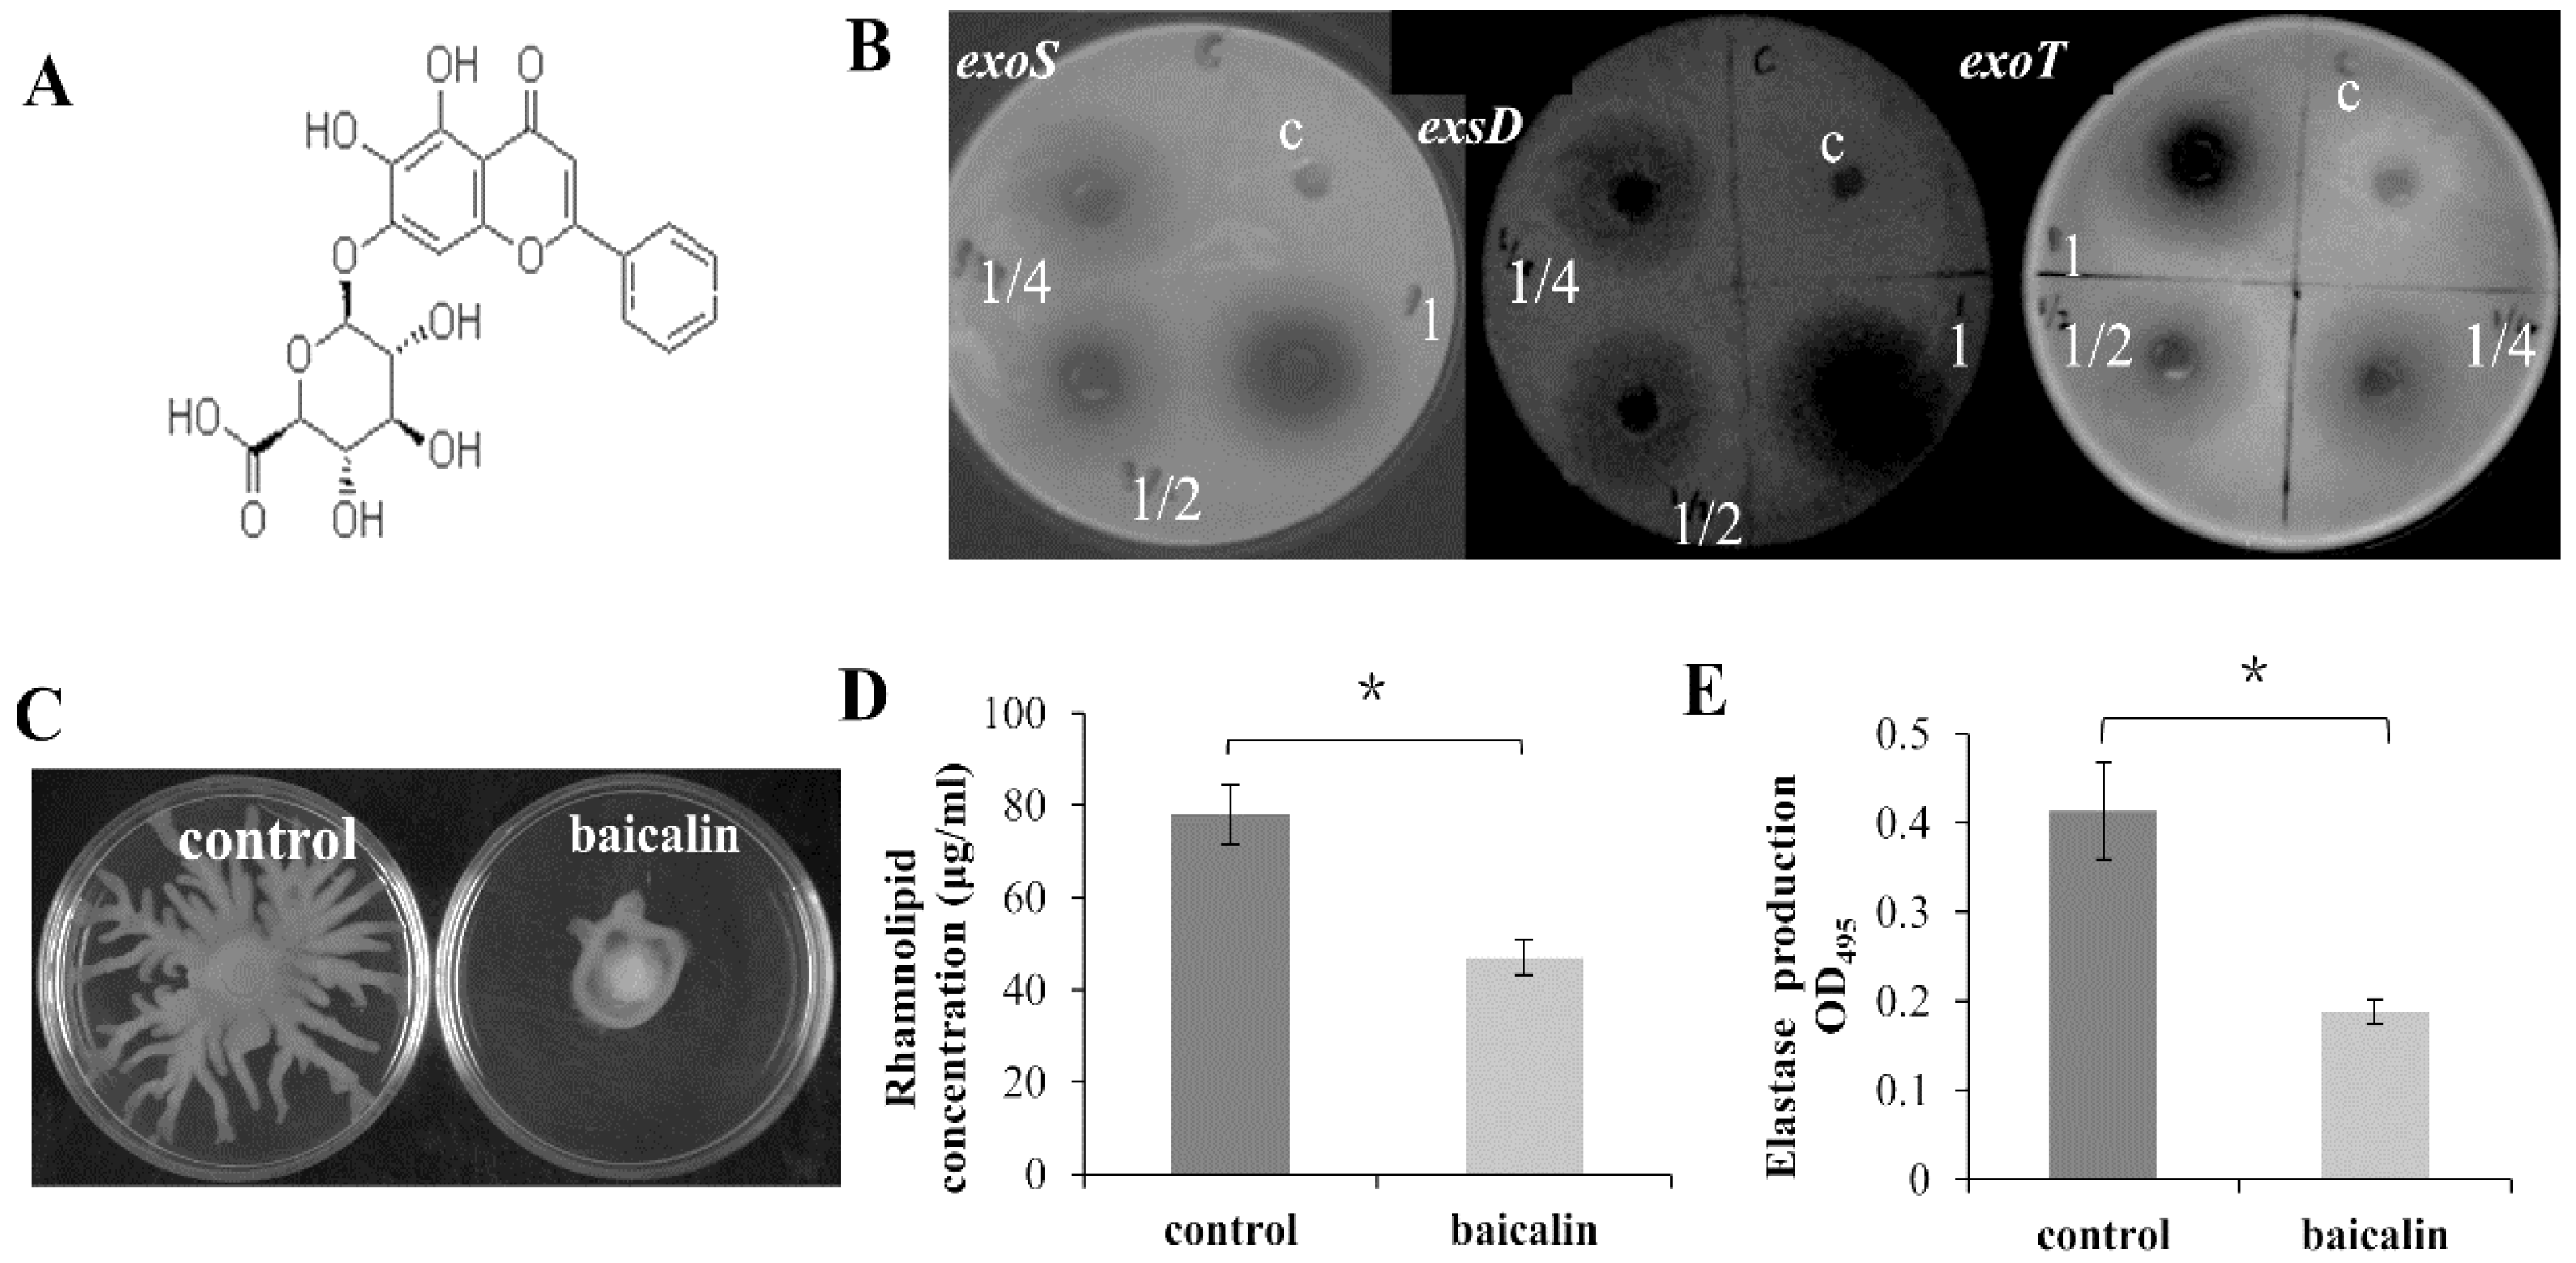
Molecules 26 01497 g002 Molecules 26 01497 g002

Baicalin Represses Type Three Secretion System of Pseudomonas aeruginosa through PQS System
Abstract
1. Introduction
2. Results
2.1. The Effect of Crude Extracts on Virulence Factors in P. aeruginosa PAO1
2.2. The Extract of Scutellariae Radix Reduces Swarming Motility, but Has No Effect on Swimming and Twitching Motilities
2.3. Baicalin Inhibits the Expression of Virulence Factors in P. aeruginosa
2.4. Reduction of the Cellular Toxicity of PAO1 on the Mammalian Cell by Baicalin
2.5. Baicalin Attenuates the Pathogenicity of PAO1 in the Fruit Fly Model
2.6. Baicalin Attenuates the Pathogenicity of P. aeruginosa PAO1 and Host Inflammatory Response in the Rat Pulmonary Infection Model
2.7. Baicalin Exerted Its Impact on T3SS via PqsR of the PQS System
3. Discussion
4. Materials and Methods
4.1. Bacterial Strains and Culture Conditions
4.2. Plant Extraction
4.3. Expression Monitoring Assay
4.4. Motility Assays
4.5. Elastase Assay
4.6. Rhamnolipid Assay
4.7. Cytotoxicity Measurement
4.8. Fly Infections Model
4.9. The Rat Pulmonary Infection Model
4.10. Macroscopic Description of the Lungs
4.11. Histopathological Studies and Quantitative Bacteriology
4.12. ELISA
4.13. Statistical Analysis
5. Patents
Supplementary Materials
Author Contributions
Funding
Institutional Review Board Statement
Informed Consent Statement
Data Availability Statement
Conflicts of Interest
Sample Availability
References
- Schulert, G.S.; Feltman, H.; Rabin, S.D.P.; Martin, C.G.; Battle, S.E.; Rello, J.; Hauser, A.R. Secretion of the Toxin ExoU Is a Marker for Highly Virulent Pseudomonas aeruginosa Isolates Obtained from Patients with Hospital-Acquired Pneumonia. J. Infect. Dis. 2003, 188, 1695–1706. [Google Scholar] [CrossRef] [PubMed]
- Coburn, B.; Sekirov, I.; Finlay, B.B. Type III Secretion Systems and Disease. Clin. Microbiol. Rev. 2007, 20, 535–549. [Google Scholar] [CrossRef] [PubMed]
- Hauser, A.R. The type III secretion system of Pseudomonas aeruginosa: Infection by injection. Nat. Rev. Microbiol. 2009, 7, 654–665. [Google Scholar] [CrossRef] [PubMed]
- Goure, J.; Pastor, A.; Faudry, E.; Chabert, J.; Dessen, A.; Attree, I. The V Antigen of Pseudomonas aeruginosa is required for Assembly of the Functional PopB/PopD Translocation Pore in Host Cell Membranes. Infect. Immun. 2004, 72, 4741–4750. [Google Scholar] [CrossRef] [PubMed]
- Sawa, T.; Yahr, T.L.; Ohara, M.; Kurahashi, K.; Gropper, M.A.; Wiener-Kronish, J.P.; Frank, D.W. Active and passive immunization with the Pseudomonas V antigen protects against type III intoxication and lung injury. Nat. Med. 1999, 5, 392–398. [Google Scholar] [CrossRef]
- Holder, I.A.; Neely, A.N.; Frank, D.W. PcrV Immunization Enhances Survival of Burned Pseudomonas aeruginosa-Infected Mice. Infect. Immun. 2001, 69, 5908–5910. [Google Scholar] [CrossRef]
- Fuqua, C.; Parsek, M.R.; Greenberg, E.P. Regulation of gene expression by cell-to-cell communication: Acyl-homoserine lac-tone quorum sensing. Annu. Rev. Genet. 2001, 35, 439–468. [Google Scholar] [CrossRef]
- Diggle, S.P.; Cornelis, P.; Williams, P.; Cámara, M. 4-Quinolone signalling in Pseudomonas aeruginosa: Old molecules, new perspectives. Int. J. Med. Microbiol. 2006, 296, 83–91. [Google Scholar] [CrossRef] [PubMed]
- Williams, P.; Winzer, K.; Chan, W.C.; Camara, M. Look who’s talking: Communication and quorum sensing in the bacterial world. Philos. Trans. R. Soc. B 2007, 362, 1119–1134. [Google Scholar] [CrossRef] [PubMed]
- Deziel, E.; Lepine, F.; Milot, S.; He, J.; Mindrinos, M.N.; Tompkins, R.G.; Rahme, L.G. Analysis of Pseudomonas aeruginosa 4-hydroxy-2-alkylquinolines (HAQs) reveals a role for 4-hydroxy-2-heptylquinoline in cell-to-cell communication. Proc. Natl. Acad. Sci. USA 2004, 101, 1339–1344. [Google Scholar] [CrossRef]
- Diggle, S.P.; Winzer, K.; Chhabra, S.R.; Worrall, K.E.; Cámara, M.; Williams, P. The Pseudomonas aeruginosa quinolone signal molecule overcomes the cell density-dependency of the quorum sensing hierarchy, regulates rhl-dependent genes at the onset of stationary phase and can be produced in the absence of LasR. Mol. Microbiol. 2003, 50, 29–43. [Google Scholar] [CrossRef] [PubMed]
- Pesci, E.C.; Milbank, J.B.J.; Pearson, J.P.; McKnight, S.; Kende, A.S.; Greenberg, E.P.; Iglewski, B.H. Quinolone signaling in the cell-to-cell communication system of Pseudomonas aeruginosa. Proc. Natl. Acad. Sci. USA 1999, 96, 11229–11234. [Google Scholar] [CrossRef] [PubMed]
- Bleves, S.; Soscia, C.; Nogueira-Orlandi, P.; Lazdunski, A.; Filloux, A. Quorum Sensing Negatively Controls Type III Secretion Regulon Expression in Pseudomonas aeruginosa PAO1. J. Bacteriol. 2005, 187, 3795–3799. [Google Scholar] [CrossRef]
- Brencic, A.; Mcfarland, K.A.; Mcmanus, H.R.; Castang, S.; Mogno, I.; Dove, S.L.; Lory, S. The GacS/GacA signal transduction system of Pseudomonas aeruginosa acts exclusively through its control over the transcription of the RsmY and RsmZ regulatory small RNAs. Mol. Microbiol. 2009, 73, 434–445. [Google Scholar] [CrossRef] [PubMed]
- Bhagirath, A.Y.; Pydi, S.P.; Li, Y.; Lin, C.; Kong, W.; Chelikani, P.; Duan, K. Characterization of the Direct Interaction between Hybrid Sensor Kinases PA1611 and RetS That Controls Biofilm Formation and the Type III Secretion System in Pseudomonas aeruginosa. ACS Infect. Dis. 2016, 3, 162–175. [Google Scholar] [CrossRef]
- Egan, M.E.; Pearson, M.; Weiner, S.A.; Rajendran, V.; Rubin, D.; Glöckner-Pagel, J.; Canny, S.; Du, K.; Lukacs, G.L.; Caplan, M.J. Curcumin, a Major Constituent of Turmeric, Corrects Cystic Fibrosis Defects. Science 2004, 304, 600–602. [Google Scholar] [CrossRef] [PubMed]
- Shen, Z.X.; Chen, G.Q.; Ni, J.H.; Li, X.S.; Xiong, S.M.; Qiu, Q.Y.; Zhu, J.; Tang, W.; Sun, G.L.; Yang, K.Q.; et al. Use of arsenic trioxide (As2O3) in the treatment of acute promyelocytic leukemia (APL): II. Clinical efficacy and pharmacokinetics in relapsed patients. Blood 1997, 89, 3354–3360. [Google Scholar] [CrossRef]
- Eckstein-Ludwig, U.; Webb, R.; Van Goethem, I.; East, J.; Lee, A.; Kimura, M.; O’Neill, P.; Bray, P.; Ward, S.; Krishna, S. Ar-temisinins target the SERCA of Plasmodium falciparum. Nature 2003, 424, 957–961. [Google Scholar] [CrossRef]
- Brown, J. A review of the genetic effects of naturally occurring flavonoids, anthraquinones and related compounds. Mutat. Res. Genet. Toxicol. 1980, 75, 243–277. [Google Scholar] [CrossRef]
- Cushnie, T.T.; Hamilton, V.E.; Lamb, A.J. Assessment of the antibacterial activity of selected flavonoids and consideration of discrepancies between previous reports. Microbiol. Res. 2003, 158, 281–289. [Google Scholar] [CrossRef]
- Sithisarn, P.; Rojsanga, P.; Sithisarn, P. Inhibitory Effects on Clinical Isolated Bacteria and Simultaneous HPLC Quantitative Analysis of Flavone Contents in Extracts from Oroxylum indicum. Molecules 2019, 24, 1937. [Google Scholar] [CrossRef] [PubMed]
- Brackman, G.; Cos, P.; Maes, L.; Nelis, H.J.; Coenye, T. Quorum sensing inhibitors increase the susceptibility of bacterial bio-films to antibiotics in vitro and in vivo. Antimicrob. Agents Chemother. 2011, 55, 2655–2661. [Google Scholar] [CrossRef] [PubMed]
- Luo, J.; Dong, B.; Wang, K.; Cai, S.; Liu, T.; Cheng, X.; Lei, D.; Chen, Y.; Li, Y.; Kong, J.; et al. Baicalin inhibits biofilm formation, attenuates the quorum sensing-controlled virulence and enhances Pseudomonas aeruginosa clearance in a mouse peritoneal implant infection model. PLoS ONE 2017, 12, e0176883. [Google Scholar] [CrossRef] [PubMed]
- Ding, C.; Yang, Z.; Wang, J.; Liu, X.; Cao, Y.; Pan, Y.; Han, L.; Zhan, S. Prevalence of Pseudomonas aeruginosa and antimicrobial-resistant Pseudomonas aeruginosa in patients with pneumonia in mainland China: A systematic review and meta-analysis. Int. J. Infect. Dis. 2016, 49, 119–128. [Google Scholar] [CrossRef]
- Fujitani, S.; Sun, H.Y.; Yu, V.L.; Weingarten, J.A. Pneumonia due to Pseudomonas aeruginosa: Part I: Epidemiology, clinical diagnosis, and source. Chest 2011, 139, 909–919. [Google Scholar] [CrossRef]
- Bhagirath, A.Y.; Li, Y.; Somayajula, D.; Dadashi, M.; Badr, S.; Duan, K. Cystic fibrosis lung environment and Pseudomonas aeruginosa infection. BMC Pulm. Med. 2016, 16, 1–22. [Google Scholar] [CrossRef]
- Lansbury, L.; Lim, B.; Baskaran, V.; Lim, W.S. Co-infections in people with COVID-19: A systematic review and meta-analysis. J. Infect. 2020, 81, 266–275. [Google Scholar] [CrossRef]
- Liang, H.; Li, L.; Kong, W.; Shen, L.; Duan, K. Identification of a novel regulator of the quorum-sensing systems in Pseudomonas aeruginosa. FEMS Microbiol. Lett. 2009, 293, 196–204. [Google Scholar] [CrossRef]
- Köhler, T.; Curty, L.K.; Barja, F.; Van Delden, C.; Pechère, J.-C. Swarming of Pseudomonas aeruginosa Is Dependent on Cell-to-Cell Signaling and Requires Flagella and Pili. J. Bacteriol. 2000, 182, 5990–5996. [Google Scholar] [CrossRef]
- Déziel, E.; Lépine, F.; Milot, S.; Villemur, R. rhlA is required for the production of a novel biosurfactant promoting swarming motility in Pseudomonas aeruginosa: 3-(3-hydroxyalkanoyloxy) alkanoic acids (HAAs), the precursors of rhamnolipids. Microbiology 2003, 149, 2005–2013. [Google Scholar] [CrossRef]
- Xiping, Z.; Tianmei, Z.; Xiaoqing, D. Experimental Study on Antibacterial Effect of Baicalin Injection in vitro. J. Med. Res. 2006, 8, 14. [Google Scholar]
- Kharazmi, A. Interactions of Pseudomonas aeruginosa Proteases with the Cells of the Immune System. Antibiot. Chemother. 1989, 42, 42–49. [Google Scholar] [CrossRef] [PubMed]
- Kong, W.; Liang, H.; Shen, L.; Duan, K. Regulation of type III secretion system by Rhl and PQS quorum sensing systems in Pseudomonas aeruginosa. Wei Sheng Wu Xue Bao 2009, 49, 1158–1164. [Google Scholar]
- E Clatworthy, A.; Pierson, E.; Hung, D.T. Targeting virulence: A new paradigm for antimicrobial therapy. Nat. Chem. Biol. 2007, 3, 541–548. [Google Scholar] [CrossRef] [PubMed]
- Lee, V.T.; Pukatzki, S.; Sato, H.; Kikawada, E.; Kazimirova, A.A.; Huang, J.; Li, X.; Arm, J.P.; Frank, D.W.; Lory, S. Pseudolipasin A is a specific inhibitor for phospholipase A2 activity of Pseudomonas aeruginosa cytotoxin ExoU. Infect. Immun. 2007, 75, 1089–1098. [Google Scholar] [CrossRef] [PubMed]
- Arnoldo, A.; Curak, J.; Kittanakom, S.; Chevelev, I.; Lee, V.T.; Sahebol-Amri, M.; Koscik, B.; Ljuma, L.; Roy, P.J.; Bedalov, A. Identification of small molecule inhibitors of Pseudomonas aeruginosa exoenzyme S using a yeast phenotypic screen. PLoS Genet. 2008, 4, e1000005. [Google Scholar] [CrossRef]
- Aiello, D.; Williams, J.D.; Majgier-Baranowska, H.; Patel, I.; Peet, N.P.; Huang, J.; Lory, S.; Bowlin, T.L.; Moir, D.T. Discovery and Characterization of Inhibitors of Pseudomonas aeruginosa Type III Secretion. Antimicrob. Agents Chemother. 2010, 54, 1988–1999. [Google Scholar] [CrossRef]
- Zhang, P.; Wu, Q.; Chen, L.; Duan, K. Virulence-Inhibiting Herbal Compound Falcarindiol Significantly Reduced Mortality in Mice Infected with Pseudomonas aeruginosa. Antibiotics 2020, 9, 136. [Google Scholar] [CrossRef]
- Rasmussen, T.B.; Bjarnsholt, T.; Skindersoe, M.E.; Hentzer, M.; Kristoffersen, P.; Köte, M.; Nielsen, J.; Eberl, L.; Givskov, M. Screening for Quorum-Sensing Inhibitors (QSI) by Use of a Novel Genetic System, the QSI Selector. J. Bacteriol. 2005, 187, 1799–1814. [Google Scholar] [CrossRef]
- Shao, X.; Xie, Y.; Zhang, Y.; Liu, J.; Ding, Y.; Wu, M.; Wang, X.; Deng, X. Novel therapeutic strategies for treating Pseudomonas aeruginosa infection. Expert Opin. Drug Discov. 2020, 15, 1403–1423. [Google Scholar] [CrossRef]
- Shaw, E.; Wuest, W.M. Virulence attenuating combination therapy: A potential multi-target synergy approach to treat Pseu-domonas aeruginosa infections in cystic fibrosis patients. RSC Med. Chem. 2020, 11, 358–369. [Google Scholar] [CrossRef] [PubMed]
- Sawa, T.; Ohara, M.; Kurahashi, K.; Twining, S.S.; Frank, D.W.; Doroques, D.B.; Long, T.; Gropper, M.A.; Wiener-Kronish, J.P. In vitro Cellular Toxicity Predicts Pseudomonas aeruginosa Virulence in Lung Infections. Infect. Immun. 1998, 66, 3242–3249. [Google Scholar] [CrossRef] [PubMed]
- Yamazaki, A.; Li, J.; Zeng, Q.; Khokhani, D.; Hutchins, W.C.; Yost, A.C.; Biddle, E.; Toone, E.J.; Chen, X.; Yang, C.-H. Deriv-atives of plant phenolic compound affect the type III secretion system of Pseudomonas aeruginosa via a GacS-GacA two-component signal transduction system. Antimicrob. Agents Chemother. 2012, 56, 36–43. [Google Scholar] [CrossRef] [PubMed]
- Kong, W.; Chen, L.; Zhao, J.; Shen, T.; Surette, M.G.; Shen, L.; Duan, K. Hybrid sensor kinase PA1611 in Pseudomonas aeruginosa regulates transitions between acute and chronic infection through direct interaction with RetS. Mol. Microbiol. 2013, 88, 784–797. [Google Scholar] [CrossRef] [PubMed]
- Pearson, J.P.; Pesci, E.C.; Iglewski, B.H. Roles of Pseudomonas aeruginosa las and rhl quorum-sensing systems in control of elastase and rhamnolipid biosynthesis genes. J. Bacteriol. 1997, 179, 5756–5767. [Google Scholar] [CrossRef]
- Brint, J.M.; Ohman, D.E. Synthesis of multiple exoproducts in Pseudomonas aeruginosa is under the control of RhlR-RhlI, an-other set of regulators in strain PAO1 with homology to the autoinducer-responsive LuxR-LuxI family. J. Bacteriol. 1995, 177, 7155–7163. [Google Scholar] [CrossRef]
- Duan, K.; Dammel, C.; Stein, J.; Rabin, H.; Surette, M.G. Modulation of Pseudomonas aeruginosa gene expression by host mi-croflora through interspecies communication. Mol. Microbiol. 2003, 50, 1477–1491. [Google Scholar] [CrossRef] [PubMed]
- Hoang, T.T.; Karkhoff-Schweizer, R.R.; Kutchma, A.J.; Schweizer, H.P. A broad-host-range Flp-FRT recombination system for site-specific excision of chromosomally-located DNA sequences: Application for isolation of unmarked Pseudomonas aeruginosa mutants. Gene 1998, 212, 77–86. [Google Scholar] [CrossRef]
- Duan, K.; Surette, M.G. Environmental Regulation of Pseudomonas aeruginosa PAO1 Las and Rhl Quorum-Sensing Systems. J. Bacteriol. 2007, 189, 4827–4836. [Google Scholar] [CrossRef]
- Liang, H.; Li, L.; Dong, Z.; Surette, M.G.; Duan, K. The YebC Family Protein PA0964 Negatively Regulates the Pseudomonas aeruginosa Quinolone Signal System and Pyocyanin Production. J. Bacteriol. 2008, 190, 6217–6227. [Google Scholar] [CrossRef]
- Shen, L.; Gao, X.; Wei, J.; Chen, L.; Zhao, X.; Li, B.; Duan, K. PA2800 Plays an Important Role in Both Antibiotic Susceptibility and Virulence in Pseudomonas aeruginosa. Curr. Microbiol. 2012, 65, 601–609. [Google Scholar] [CrossRef]
- Rashid, M.H.; Kornberg, A. Inorganic polyphosphate is needed for swimming, swarming, and twitching motilities of Pseudo-monas aeruginosa. Proc. Natl. Acad. Sci. USA 2000, 97, 4885–4890. [Google Scholar] [CrossRef]
- Ohman, D.; Cryz, S.J.; Iglewski, B.H. Isolation and characterization of Pseudomonas aeruginosa PAO mutant that produces altered elastase. J. Bacteriol. 1980, 142, 836–842. [Google Scholar] [CrossRef] [PubMed]
- Guerra-Santos, L.H.; Kappeli, O.; Fiechter, A. Dependence of Pseudomonas aeruginosa continous culture biosurfactant produc-tion on nutritional and environmental factors. Appl. Microbiol. Biotechnol. 1986, 24, 443–448. [Google Scholar] [CrossRef]
- Koch, A.K.; Kappeli, O.; Fiechter, A.; Reiser, J. Hydrocarbon assimilation and biosurfactant production in Pseudomonas aeru-ginosa mutants. J. Bacteriol. 1991, 173, 4212–4219. [Google Scholar] [CrossRef]
- Chugani, S.A.; Whiteley, M.; Lee, K.M.; D’Argenio, D.; Manoil, C.; Greenberg, E. QscR, a modulator of quorum-sensing signal synthesis and virulence in Pseudomonas aeruginosa. Proc. Natl. Acad. Sci. USA 2001, 98, 2752–2757. [Google Scholar] [CrossRef]
- Wu, H.; Song, Z.; Hentzer, M.; Andersen, J.B.; Heydorn, A.; Mathee, K.; Moser, C.; Eberl, L.; Molin, S.; Høiby, N.; et al. Detection of N-acylhomoserine lactones in lung tissues of mice infected with Pseudomonas aeruginosa. Microbiology 2000, 146, 2481–2493. [Google Scholar] [CrossRef][Green Version]
- Bjarnsholt, T.; Van Gennip, M.; Jakobsen, T.H.; Christensen, L.D.; Jensen, P.Ø.; Givskov, M. In vitro screens for quorum sensing inhibitors and in vivo confirmation of their effect. Nat. Protoc. 2010, 5, 282–293. [Google Scholar] [CrossRef] [PubMed]
- Johansen, H.K.; Espersen, F.; Pedersen, S.S.; Hougen, H.P.; Rygaard, J.; Høiby, N. Chronic Pseudomonas aeruginosa lung infection in normal and athymic rats. APMIS 1993, 101, 207–225. [Google Scholar] [CrossRef] [PubMed]

| Treatment Group | Scoring of Lungs According to Severity of Inflammation Maroscopic Mean |
|---|---|
| NaCl | 1.1 *** (p = 0.0002) |
| Cefepime | 1.3 * (p = 0.01) |
| Model | 1.9 |
| Baicalin | 1.4 * (p = 0.02) |
| Treatment Group | Range of log.CFU. per Organ (CFU) (Median) |
|---|---|
| Cefepime | (0–1.1) 0 ** (p = 0.001) |
| Untreated model | (0–5.5) 3.1 |
| Baicalin | (0–3.3) 0 * (p = 0.04) |
| Strains or Plasmids | Relevant Characteristics | Source or Reference |
|---|---|---|
| Strains | ||
| PAO1 | Wild type | |
| PAO1(ΔpqsR) | pqsR mutation of PAO1 | [28] |
| PAO1(ΔpqsH) | pqsH mutation of PAO1 | This study |
| PAO1(ΔretS) | retS mutation of PAO1 | [44] |
| PAO1(ΔgacA) | gacA mutation of PAO1 | [44] |
| PAO214 | lasI mutation of PAO1 | [45] |
| PDO100 | rhlI mutation of PAO1 | [46] |
| Plasmids | ||
| pMS402 | Expression reporter plasmid with the promoterless luxCDABE gene; Knr, Tmpr | [47] |
| CTX6.1 | Integration plasmid with the mini-CTX-lux backbone; Tcr | This lab |
| pRK2013 | Helper vector in triparental conjugation; Tra+, Knr | [48] |
| pkD-pilG | pilG promoter was inserted into pMS402; Knr, Tmpr | [47] |
| pkD-fliC | fliC promoter was inserted into pMS402; Knr, Tmpr | [47] |
| pkD-rhlA | rhlA promoter was inserted into pMS402; Knr, Tmpr | [47] |
| pkD-phzA1 | phzA1promoter was inserted into pMS402; Knr, Tmpr | [47] |
| pkD-phzA2 | phzA2 promoter was inserted into pMS402; Knr, Tmpr | [47] |
| pkD-lasI | lasI promoter was inserted into pMS402; Knr, Tmpr | [49] |
| pkD-rhlI | rhlI promoter was inserted into pMS402; Knr, Tmpr | [49] |
| pkD-lasR | lasR promoter was inserted into pMS402; Knr, Tmpr | [49] |
| pkD-rhlR | rhlR promoter was inserted into pMS402; Knr, Tmpr | [49] |
| pkD-rhlA | rhlA promoter was inserted into pMS402; Knr, Tmpr | [47] |
| pKD-lasA | lasA promoter was inserted into pMS402; Knr, Tmpr | [47] |
| pkD-lasB | lasB promoter was inserted into pMS402; Knr, Tmpr | [47] |
| pkD-rsmA | rsmA promoter was inserted into pMS402; Knr, Tmpr | This lab |
| pkD-rsmY | rsmY promoter was inserted into pMS402; Knr, Tmpr | This lab |
| pkD-rsmZ | rsmZ promoter was inserted into pMS402; Knr, Tmpr | This lab |
| pKD-gacA | gacA promoter was inserted into pMS402; Knr, Tmpr | [44] |
| pKD-rpoS | rpoS promoter was inserted into pMS402; Knr, Tmpr | [47] |
| pkD-pilG | pilG promoter was inserted into pMS402; Knr, Tmpr | [47] |
| pkD-fliC | fliC promoter was inserted into pMS402; Knr, Tmpr | [47] |
| pKD-pqsA | pqsA promoter was inserted into pMS402; Knr, Tmpr | [50] |
| pkD-pqsR | pqsR promoter was inserted into pMS402; Knr, Tmpr | [50] |
| pkD-pqsH | pqsH promoter was inserted into pMS402; Knr, Tmpr | [28] |
| pkD-oprH | oprH promoter was inserted into pMS402; Knr, Tmpr | [47] |
| pkD-exoS | exoS promoter was inserted into pMS402; Knr, Tmpr | [47] |
| pkD-exoY | exoY promoter was inserted into pMS402; Knr, Tmpr | [47] |
| pkD-exoT | exoT promoter was inserted into pMS402; Knr, Tmpr | [47] |
| pkD-exsD | exsD promoter was inserted into pMS402; Knr, Tmpr | [44] |
| pkD-exsC | exsC promoter was inserted into pMS402; Knr, Tmpr | [44] |
| pkD-aprA | aprA promoter was inserted into pMS402; Knr, Tmpr | [47] |
| pkD-migA | migA promoter was inserted into pMS402; Knr, Tmpr | [47] |
| pkD-oprH | oprH promoter was inserted into pMS402; Knr, Tmpr | [47] |
| pkD-rnr | rnr promoter was inserted into pMS402; Knr, Tmpr | [47] |
| pkD-xcpR | xcpR promoter was inserted into pMS402; Knr, Tmpr | [47] |
| ctx-exoS | Integration plasmid, exoS promoter with promoterless luxCDABE gene was inserted into CTX6.1; Knr, Tmpr, Tcr | This lab |
| ctx-phzA1 | Integration plasmid, phzA1 promoter with promoterless luxCDABE gene was inserted into CTX6.1; Knr, Tmpr, Tcr | This lab |
| ctx-phzA2 | Integration plasmid, phzA2 promoter with promoterless luxCDABE gene was inserted into CTX6.1; Knr, Tmpr, Tcr | This lab |
| ctx-vfr | Integration plasmid, vfr promoter with promoterless luxCDABE gene was inserted into CTX6.1; Knr, Tmpr, Tcr | This lab |
Publisher’s Note: MDPI stays neutral with regard to jurisdictional claims in published maps and institutional affiliations. |
© 2021 by the authors. Licensee MDPI, Basel, Switzerland. This article is an open access article distributed under the terms and conditions of the Creative Commons Attribution (CC BY) license (http://creativecommons.org/licenses/by/4.0/).
Share and Cite
Zhang, P.; Guo, Q.; Wei, Z.; Yang, Q.; Guo, Z.; Shen, L.; Duan, K.; Chen, L. Baicalin Represses Type Three Secretion System of Pseudomonas aeruginosa through PQS System. Molecules 2021, 26, 1497. https://doi.org/10.3390/molecules26061497
Zhang P, Guo Q, Wei Z, Yang Q, Guo Z, Shen L, Duan K, Chen L. Baicalin Represses Type Three Secretion System of Pseudomonas aeruginosa through PQS System. Molecules. 2021; 26(6):1497. https://doi.org/10.3390/molecules26061497
Chicago/Turabian StyleZhang, Pansong, Qiao Guo, Zhihua Wei, Qin Yang, Zisheng Guo, Lixin Shen, Kangmin Duan, and Lin Chen. 2021. "Baicalin Represses Type Three Secretion System of Pseudomonas aeruginosa through PQS System" Molecules 26, no. 6: 1497. https://doi.org/10.3390/molecules26061497
APA StyleZhang, P., Guo, Q., Wei, Z., Yang, Q., Guo, Z., Shen, L., Duan, K., & Chen, L. (2021). Baicalin Represses Type Three Secretion System of Pseudomonas aeruginosa through PQS System. Molecules, 26(6), 1497. https://doi.org/10.3390/molecules26061497

